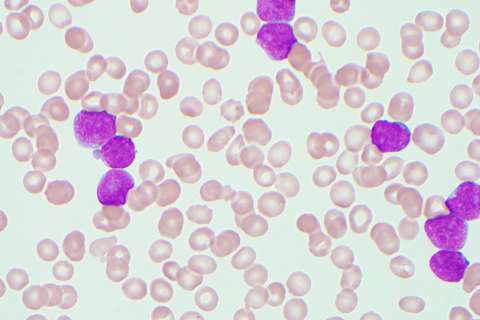
B-lymphoblastic leukemia cells

Dinesh Rao, MD, PhD
Specialty
Institutional Affiliation
Languages
Education
Fellowship
Degrees
Residency
Board Certifications
Contact Information
Phone
Clinical Interests
Scientific Interests
Dr. Dinesh Rao is interested in understanding the molecular underpinnings of cancer. Specifically, the processes by which the normal differentiation of cells is disrupted in cancer are of great interest. In this context, he is studying the role of non-coding RNA and post-transcriptional gene expression regulation in hematopoiesis and malignancy. His research has led to the identification of several non-coding RNA species and RNA-binding proteins that are important in acute leukemia. In addition, the exploration of novel elements of gene expression regulation in hematopoietic development has helped to highlight the complex genetic networks that are co-opted by cancer cells. Based on these mechanistic studies, novel diagnostic tools and therapeutic targets are currently being evaluated in the laboratory.
Highlighted Publications
Sharma G, Tran TM, Bansal I, Beg MS, Bhardwaj R, Bassi J, Tan Y, Jaiswal AK, Tso C, Jain A, Singh J, Chattopadhyay P, Singh A, Chopra A, Bakhshi S, Casero D, Rao DS, Palanichamy JK. RNA binding protein IGF2BP1 synergizes with ETV6-RUNX1 to drive oncogenic signaling in B-cell Acute Lymphoblastic Leukemia.J Exp Clin Cancer Res. 2023 Sep 5;42(1):231. doi: 10.1186/s13046-023 02810-1.
Ghazaryan A, Wallace JA, Tang WW, Barba C, Lee SH, Bauer KM, Nelson MC, Kim CN, Stubben C, Voth WP, Rao DS, O'Connell RM. miRNA-1 promotes acute myeloid leukemia cell pathogenesis through metabolic regulation. Front Genet. 2023 May 9;14:1192799. doi: 10.3389/fgene.2023.1192799. eCollection 2023.
Leukemia. 2022 Jan;36(1):68-79. doi: 10.1038/s41375-021 01346-7. Epub 2021 Jul 29.
Palanichamy JK, Tran TM, Howard JM, Contreras JR, Fernando TR, Sterne-Weiler T, Katzman S, Toloue M, Yan W, Basso G, Pigazzi M, Sanford JR, Rao DS. RNA-binding protein IGF2BP3 targeting of oncogenic transcripts promotes hematopoietic progenitor proliferation. J Clin Invest. 2016 Apr 1;126(4):1495-511. doi: 10.1172/JCI80046. Epub 2016 Mar 14.
Fernando TR, Rodriguez-Malave NI, Waters EV, Yan W, Casero D, Basso G, Pigazzi M, Rao DS. LncRNA Expression Discriminates Karyotype and Predicts Survival in B-Lymphoblastic Leukemia. Mol Cancer Res. 2015 May;13(5):839-51. doi: 10.1158/1541-7786.MCR-15-0006-T. Epub 2015 Feb 13.